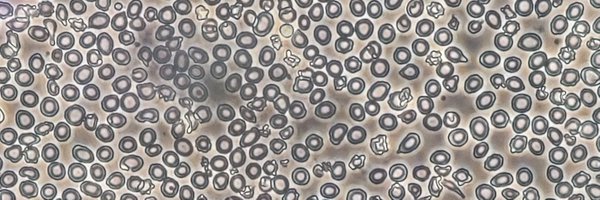
Prathibhapbc Profile Banner

Prathibha
@Prathibhapbc
Followers
116
Following
565
Media
0
Statuses
38
PhD student @ Centre for Stem Cell Research, CMC Vellore. Hematopoietic stem cells, genome editing, CRISPR🧬✂️ IISER-TVM alumna
India
Joined February 2022
New publication from our lab showing therapeutic dual-beneficial mutations gene editing for the gene therapy of sickle cell disease and β-thalassemia. https://t.co/YNgKOHRK8u
@DBTIndia @CSCR_CMC_inStem @DBT_inStem @OffCMCVellore @Prathibhapbc
#SickleCellDisease #GeneTherapy
2
3
14
Our work and my first author article is online now. We describe our therapeutic editing strategy for treating β-hemogobinopathies. Happy reading and a very happy new year :) https://t.co/1Ayl8ytIXT
@SaravanabhavanT @vigneshvnkt @CSCR_CMC_inStem @BioMedCentral
#CRISPR #GeneTherapy
1
3
19
The Hindu: Indian scientists develop novel gene therapy for haemophilia Department of Biotechnology #DBT, Ministry of Science and Technology, Government of India Read: https://t.co/arFeV3NnML
1
16
46
Inauguration of the Nari Shakti event as a part of India International Science Festival 2024 on 1st December 2024 by Hon’ble Secretary and DG, DSIR by Dr N Kalaislevi @CSIR_IND @csir_niist @IndiaDST @DBTIndia @DrJitendraSingh @moesgoi
1
8
17
#IISF2024 @IITGuwahati Day 1 The S&T Expo was inaugurated with a lighting of the lamp by @DrJitendraSingh 🪔 Our stall displayed our research, technology and programs. We had the opportunity to demonstrate 🫁 model to @DBTIndia secretary Dr @rajesh_gokhale too! A day well-spent
1
8
21
#IISF2024 @IITGuwahati Are you ready for Day 2? We are! Come visit our stall opposite to inaugural halls. @GanMut_ has a cool game for u! @Piyush_273 isn't yet out of breath about lungs. @Prathibhapbc & Dr Gurbinder are keen to explain gene therapy too! Did we say you can get
1
2
8
🧑🔬 What subjects have past winners studied? 🎂 What age were they when they won? 🌏 Where do they live? We crunched the data on how to win a Nobel Prize #NobelPrize
2
7
15
Maybe Marie Curie’s legacy is more than her 2 Nobels. In Elements of Marie Curie, Dava Sobel beautifully illuminates her dozens of scientific offspring, dozens of women physicists and chemists. My review in @Nature
https://t.co/IwEgngZhm9
23
651
2K
Read our commentary https://t.co/gWKikjTKzW on the new findings on HSPCs from Mikkola's lab & potential improvements this can bring to the hematopoietic stem cell and gene therapy. Congratulations @Prathibhapbc
#genetherapy #stemcells @CSCR_CMC_inStem @DBT_inStem @DBTIndia
0
6
12
#ARR2024 Day 2 Session Molecular Basis of Disease - Part III Dr Sarvanabhavan Thangavel of our vellore unit @CSCR_CMC_inStem spoke on “Gene-edited hematopoietic stem and progenitor cells for gene therapy for Beta-hemoglobinopathies” An engaging Q&A followed @DBTIndia
0
4
17
Student Talk #ARR2024 Day 2 Chemical Technology Session @Prathibhapbc of @SaravanabhavanT Lab spoke on "Editing the HBG promoter in hematopoietic stem and progenitor cells through homology-directed repair for β-hemoglobinopathies treatment" + Q&A @CSCR_CMC_inStem
@DBTIndia
0
3
15
Is there room for human #CRISPR gene editing beyond treating existing disease? We need answers soon based on progress in the field. @antonioregalado's piece provides serious food for thought here. Read and feel your heart rate rise - in a good way. https://t.co/gTNlqJnjmk
technologyreview.com
CRISPR will get easier and easier to administer. What does that mean for the future of our species?
7
32
51
Congrats @vigneshvnkt
I am truly honored and deeply grateful to have been selected as a recipient of the prestigious Sun Pharma Science Scholar Award. Dedicating this award to @SaravanabhavanT and the team for their constant support. Thanks to @SunPharma_Live for giving me this opportunity.
1
0
3
Hayao Miyazaki wrote Spirited Away for and about his grand daughter who he felt was losing appreciation in things.
50
8K
59K
When Marina Abramovic placed herself at the mercy of a crowd of strangers in an art studio in Naples in 1974, she had no idea what to expect. She stood before them with a sign that read: “There are 72 objects on the table that one can use on me as desired. Performance. I am
233
801
8K
The latest on human total body cell count and cell size derived from >1,500 sources @PNASNews Men ~36 trillion cells Women ~28 trillion cells an inverse relationship between cell size and count https://t.co/i9qKqFOaVB
9
319
892
My husband told me I talk about epigenetics too much… I told him I didn’t like histone
42
290
3K
I don't know if my eyes are slightly tainted because I'm a Malayali but do you also feel like Onam is becoming bigger each year with more and more people embracing it? Non mallus are happily enjoying sadhyas, wearing traditional clothes and making pookalams. Loving this 😍
65
72
1K
elite private schools in India are the pipeline of caste apartheid.
SC, ST, OBC students have dismal representation in private schools Attached is the school report card of DPS Mathura Road, New Delhi School %SC Students = 3.86% %ST Students = 0.57% %OBC Students = 4.34% Also it can be seen that even among faculty the representation is very
2
31
139
not all of us are raised with books, literature, classics and a reading culture around us. it's fine. reading comprehension is a cultivable skill. in fact, the bulk of my reading comprehension skills have emerged during the four years I worked on my doctoral work, imo.
6
53
686